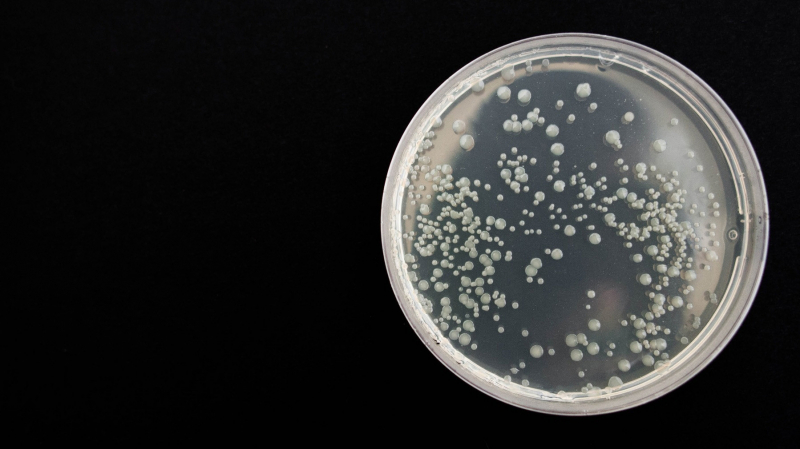
Бактерии бартонеллы выявили в крови у людей с шизофренией

Бактерии бартонеллы выявили в крови у людей с шизофренией
Бактерии бартонеллы выявили в крови у людей с шизофренией
Американские ученые в ходе экспериментального исследования выявили бактерии бартонеллы, которые могут спровоцировать развитие шизофрении и шизоаффективного расстройства.
Специалисты из университета штата Северная Каролина совместно с коллегами из университета Северной Каролины в Чапел-Хилле проанализировали образцы крови, взятые у 17 человек с медикаментозно контролируемой шизофренией и шизоаффективным расстройством. В качестве контрольной группы были отобраны 13 здоровых взрослых людей.
В результате у 12 из 17 пациентов с шизофренией обнаружили в крови бартонеллы. Признаки инфекции также зафиксировали у представителя контрольной группы. При этом в обеих группах подтвердили наличие домашних животных, у которых когда-то могли быть блохи. Науке известно, что бактерии бартонеллы могут передаваться людям через кошачьи царапины.
Comments are closed.